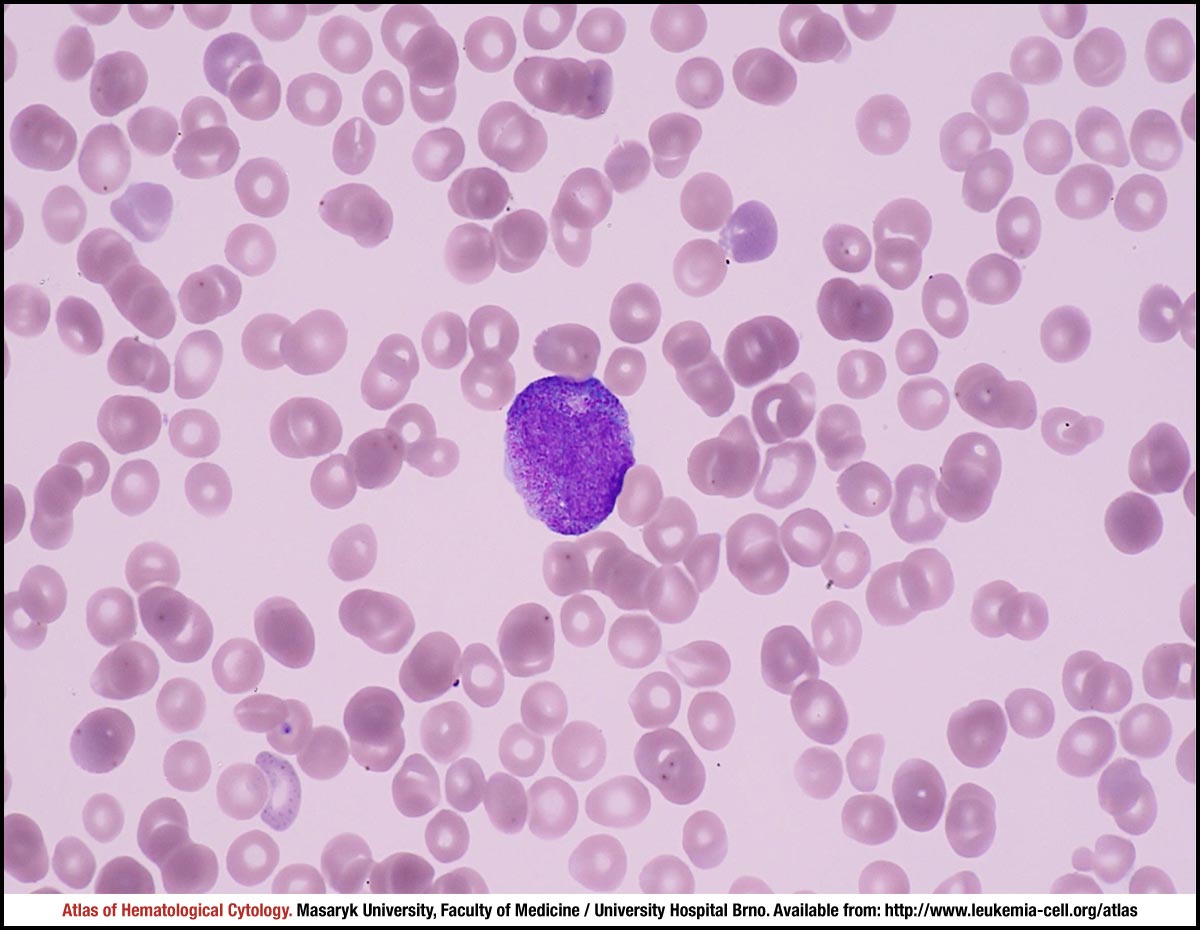
آزمایشگاه چکاپ

تجربه یک آزمایش بی نقص
آزمایشگاه چکاپ
قابل اعتماد ، علمی ، پشتیبان
كرج، چهارراه طالقانی ، ابتداي طالقانی جنوبی
آزمایشگاه تشخیص پزشکی و تخصصی چکاپ
آزمایشگاه چکاپ: قابل اعتماد، پاسخگو و علمی
آزمایشگاه چکاپ یکی از بهروزترین آزمایشگاههای شهر کرج میباشد. با تکیه بر پرسنل با تجربه و توانمندی که تحت مدیریت دکتر پرویز فلاح فعالیت میکنند، خدمات متمایز و با کیفیتی به شما ارائه میدهد.
این آزمایشگاه سه رویکرد را به عنوان اصول اصلی خود در نظر گرفته است: قابلاعتماد بودن و دقت در انجام آزمایشها، علمی بودن و همچنین پشتیبانی و پاسخگو بودن.
آزمایشگاه چکاپ (checkup lab) قادر به انجام تمامی آزمایشهای روتین در زمینههای هماتولوژی ( خون شناسی )، تشخیص مولکولی، فلوسایتومتری، بیوشیمی، هورمونشناسی و میکروبیولوژی است و به منظور رفاه حال مراجعین محترم، امکاناتی نظیر نمونهبرداری در محل و پاسخدهی آنلاین را برای مراجعین عزیز فراهم آورده است.
-
- آزمایشگاه تخصصی هماتولوژی
-
- تجهیزات پیشرفته و به روز
-
- پرسنل توانمند و متخصص
-
- قابل اعتماد ، علمی ، پشتیبان
-
- پذیرش آنلاین و حضوری
-
- بخش پذیرش آزمایشگاه
معرفی آزمایشگاه چکاپ
چرا چکاپ را انتخاب کنیم ؟
رویکرد آزمایشگاه چکاپ ارائه خدمات متمایز و با کیفیت بالا به مراجعین محترم است. اولین اصل در آزمایشگاه چکاپ ارائه بهترین و با کیفیت ترین خدمات بر اساس اصول علمی با رعایت دقیق ترین اصول کنترل کیفیت است. تیم فنی آزمایشگاه چکاپ همواره در تلاش هستند که دقیق ترین نتایج را به شما ارائه کرده و اعتماد شما ارزنده ترین دارایی آزمایشگاه چکاپ است.
بخش های آزمایشگاه
آزمایشگاه چکاپ دارای بخش های زیر است:
تیم متخصصین آزمایشگاه چکاپ
برای ارائه آزمایشات دقیق، علمی و قابل اعتماد برای شما، تیمی از متخصصین در حوزه های مختلف همکاری میکنند

دکتر مهدی بزرگی
مدیر داخلی آزمایشگاه

دکتر آزاده حاجی حسنی
سرپرست بخش میکروب شناسی

دکتر علی محمدعلی
مسئول فني شيفت صبح

دکتر هادی محمدزاده
سرپرست بخش مولکولی
پنل های آزمایشگاهی آزمایشگاه چکاپ
پذیرش آنلاین - نمونه گیری در منزل
شرایط پذیرش آنلاین
یکی از مشکلات همیشگی مراجعین به آزمایشگاه های تشخیصی، زمان زیادی است که بابت تردد و انتظار در آزمایشگاه صرف میشود. به همین جهت خدمات نمونه گیری در منزل و پذیرش آنلاین برای شما فراهم شده است. برای دریافت خدمات نمونه گیری در منزل، بعد از تکمیل فرم، همکاران پذیرش با شما تماس گرفته و هماهنگی حضور را با شما انجام خواهند داد. همچنین در صورت تمایل به انجام مراحل پذیرش به صورت آنلاین و سهولت و سرعت انجام آزمایش در زمان حضور، کافی است فرم پذیرش آنلاین را تکمیل کرده و یا شماره تماس خود را در فرم تماس ثبت کنید تا همکاران ما با شما تماس گرفته و فرایند پذیرش شما را تکمیل کنند.
هدف ما رفاه حال شماست و برای این هدف همواره میکوشیم.
درخواست تماس
در صورتی که تکمیل فرم پذیرش برای شما امکان پذیر نیست، کافی است شماره تماس خود را در اینجا وارد کنید تا همکاران پذیرش ما با شما تماس گرفته و هماهنگی لازم را برای نمونه گیری در منزل انجام دهند.
آدرس و نحوه مراجعه
آدرس آزمایشگاه:
كرج، چهارراه طالقانی ، ابتداي طالقاني جنوبي، ساختمان پزشكان وليعصر
ساعات کاری:
شنبه تا چهارشنبه از ساعت 6:30 الی 20:00
پنج شنبه ها از ساعت 6:30 الی 17:00